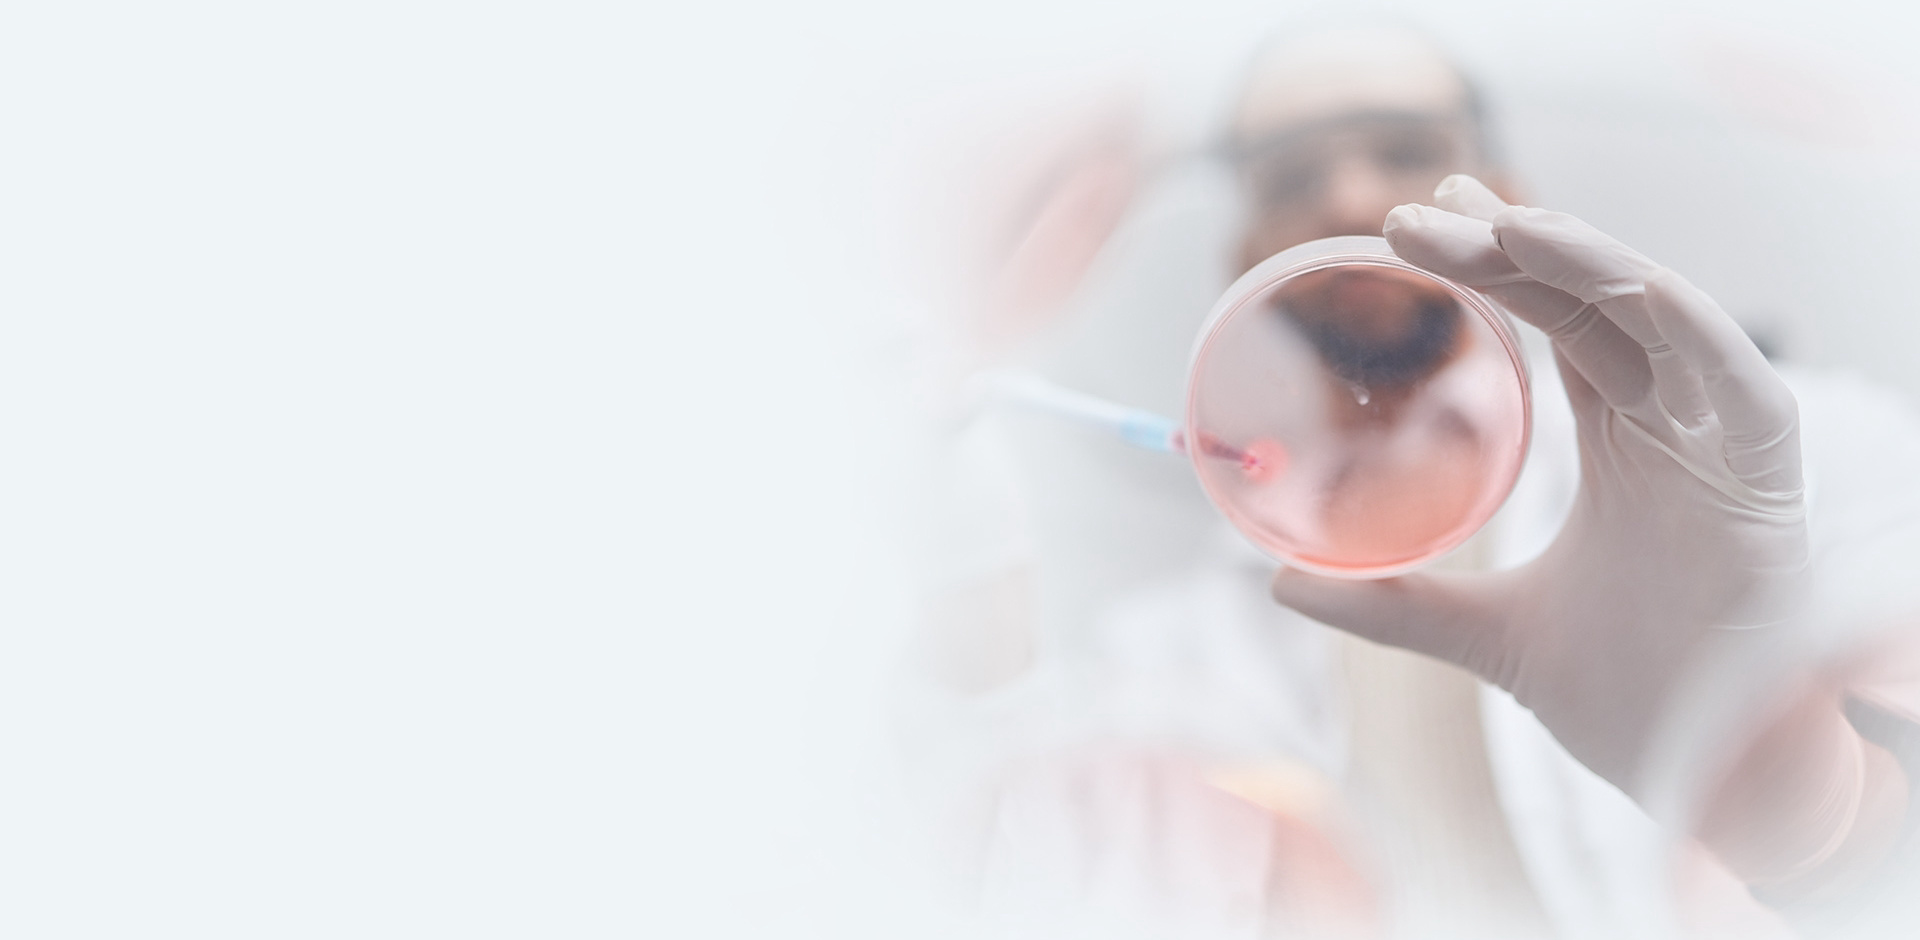
O programa

REGULAMENTO
Programa IDHentifique
Este regulamento estabelece os requisitos para a participação no Programa de Diagnóstico IDHentifique de pacientes com diagnóstico de:
- Colangiocarcinoma localmente avançado ou metastático, confirmado por biópsia;
- Glioma difuso do tipo adulto de grau 2, confirmado por biópsia;
- Leucemia Mieloide Aguda Recém Diagnosticada (De Novo), inelegível a quimioterapia intensiva, confirmado por mielograma e/ou imunofenotipagem;
- Leucemia Mieloide Aguda Recidivada/Refratária a terapia inicial, confirmados por mielograma e/ou imunofenotipagem.
O principal objetivo do programa é fornecer testes para a identificação de mutações nos genes IDH.
O Programa é desenvolvido e financiado pelo Laboratórios Servier do Brasil Ltda., inscrita no CNPJ/MF sob o número 42.374.207/0001-76, e administrado e operacionalizado pela empresa Aditus Health, inscrita no CNPJ/MF sob o número 05.297.009/0001-20 ("Aditus" ou "Gestora").
Em caso de dúvidas sobre este regulamento ou outros assuntos que envolvam o Programa, você pode enviar uma mensagem para [email protected] ou entrar em contato com a central de atendimento do Programa pelo telefone 0800 703 3431 ("Central de Atendimento").
Você também pode acessar a Política de Privacidade do Programa através dos links abaixo:
Aviso de Privacidade Pacientes
Aviso de Privacidade Médicos
A inscrição do paciente no Programa deve ser feita pelo Médico do Paciente ("Profissional Médico"), inscrito e com status regular no conselho regional de medicina e que deve ser qualificado no tratamento de pacientes com colangiocarcinoma, glioma difuso do tipo adulto e leucemia mieloide aguda. O cadastro no Programa pode ser feito gratuitamente por meio do site www.idhentifique.com.br. ("Site"). Quando cadastrado no Programa, é responsabilidade do usuário fornecer informações verdadeiras. Caso seja comprovada alguma fraude nas informações prestadas, o Programa se reserva o direito de cancelar a inscrição do usuário sem aviso prévio e a parte responsável estará sujeita às penalidades previstas na legislação vigente, além de possíveis ações judiciais e administrativas que possam ser aplicadas.
A concordância com os termos de privacidade pelo Profissional Médico e a assinatura do Termo de Consentimento constituem a aceitação plena, respectivamente, pelo Profissional Médico e pelo Paciente, dos termos e condições deste Regulamento. A Aditus Health confirmará que o consentimento do Paciente e do profissional de saúde foi obtido antes de agendar a coleta do material no qual será realizada o teste para identificação da mutação.
1. Requisitos para Participar do Programa IDHentifique
1.1. A participação do Profissional Médico no Programa está condicionada ao cumprimento das seguintes condições:
(a) Estar devidamente registrado no respectivo Conselho Regional de Medicina (CRM) do local de atuação;
(b) Ter concluído seu cadastro no Programa;
(c) Ter concordado com o Aviso de Privacidade do Médico.
1.2. As seguintes condições devem ser atendidas para concluir o processo de inscrição do paciente no Programa:
(a) O Profissional Médico deverá ter concluído a sua inscrição no Programa nos termos da cláusula 1.1 através do Site.
Colangiocarcinoma:
(b) O paciente deve ter 18 anos de idade ou mais;
(c) O paciente deve ter diagnóstico de colangiocarcinoma irressecável ou metastático, validado pelo profissional médico;
(d) O paciente deve ter um laudo anatomopatológico confirmando colangiocarcinoma ou padrão pancreatobiliar;
(e) Na ausência de laudo anatomopatológico indicando a doença, também será aceito um laudo radiológico com suspeita de colangiocarcinoma;
(f) O paciente deve ter fornecido o seu consentimento para permitir a utilização dos seus dados pessoais, incluindo dados de saúde, e autorizar a retirada do material biológico proveniente da sua biópsia para realização do teste para identificação de mutações.
Glioma difuso do tipo adulto de grau 2:
(b) O paciente deve ter entre 12 e 55 anos de idade;
(c) O paciente deve ter o diagnóstico de glioma difuso do tipo adulto validado pelo médico;
(d) O paciente deve ter um laudo anatomopatológico confirmando glioma difuso do tipo adulto de grau 2;
(e) O paciente deve ter um laudo de imuno-histoquímica com resultado negativo na pesquisa da mutação de IDH1 R132H;
(f) O paciente deve ter fornecido o seu consentimento para permitir a utilização dos seus dados pessoais, incluindo dados de saúde e autorizar a retirada do material biológico proveniente da sua biópsia para realização do teste para identificação de mutações.
Leucemia Mieloide Aguda Recém Diagnosticada e inelegível a Quimioterapia Intensiva:
(b) O paciente deve ter 18 anos de idade ou mais;
(c) Ter o diagnóstico de Leucemia Mieloide Aguda Recém Diagnosticada (De Novo), inelegível ao tratamento com regime de Quimioterapia Intensiva, com base em avaliação médica detalhada;
(d) Possuir Laudo de Mielograma ou Imunofenotipagem confirmando a doença;
(e) O paciente deve ter fornecido o seu consentimento para permitir a utilização dos seus dados pessoais, incluindo dados de saúde, e autorizar a retirada do material biológico proveniente da sua biópsia para realização do teste para identificação de mutações.
Leucemia Mieloide Aguda Recidivada/Refratária:
(b) O paciente deve ter 18 anos de idade ou mais;
(c) Ter o diagnóstico de Leucemia Mieloide Aguda Recidivada/Refratária ao tratamento inicial, com base em avaliação médica detalhada;
(d) Possuir Laudo de Mielograma ou Imunofenotipagem confirmando a doença;
(e) O paciente deve ter fornecido o seu consentimento para permitir a utilização dos seus dados pessoais, incluindo dados de saúde, e autorizar a retirada do material biológico proveniente da sua biópsia para realização do teste para identificação de mutações.
Condições da Participação
A participação no Programa está também sujeita à aceitação e concordância com os termos e condições da Política de Privacidade exposta no link da Política de Privacidade por parte do Profissional Médico.
Será permitido pelo programa a realização de 1 exame por CPF, desde que atenda a todos os critérios previstos no Regulamento do Programa. Pacientes diagnosticados com Leucemia Mieloide Aguda Recém Diagnosticada e inelegível a Quimioterapia Intensiva que realizaram o teste molecular no programa e que sua doença reapareceu ou não respondeu ao tratamento inicial (Recidivada/Refratária) poderão realizar um novo teste para identificar a presença da mutação. Será permitido ao Profissional Médico participar mais de 1 (uma) vez com Pacientes diferentes, desde que observadas as condições indicadas em 1.1 e 1.2 acima.
Os membros da equipe comercial da Servier não terão nenhuma responsabilidade ou ação em relação aos Pacientes inscritos no Programa. Seu papel será limitado a fornecer apenas materiais aprovados para Profissionais Médicos sobre os detalhes do Programa.
Quaisquer modelos de comunicação por escrito enviados pela Gestora para Profissionais Médicos ou Pacientes como parte deste Programa serão pré-aprovados pela equipe médica da Servier.
1.3 Os testes moleculares que serão realizados no material biológico do Paciente têm por objetivo avaliar características genéticas e identificar mutações (alterações) específicas que podem auxiliar o médico no tratamento do Paciente. As informações obtidas serão avaliadas pelo médico, que poderá utilizá-las para tomar decisões sobre o melhor tratamento disponível. A indicação do tratamento e sua condução são de exclusiva responsabilidade do médico do Paciente, não havendo qualquer responsabilidade da Servier, da Aditus Health e/ou dos laboratórios vinculados ao Programa nesse sentido, a qualquer título.
O objetivo do Programa é a identificação das mutações nos genes IDH, através do Sequenciamento de Nova Geração (NGS) para Colangiocarcinoma e Glioma e através da Reação de Cadeia de Polimerase (PCR) para Leucemia Mieloide Aguda. Entretanto, para pacientes com colangiocarcinoma ou glioma difuso cada laboratório parceiro fornecerá a avaliação de um pequeno painel de genes através da análise por NGS. Esses genes avaliados podem variar entre os laboratórios parceiros. Para os pacientes com leucemia mieloide difusa será fornecida apenas a identificação das mutações nos genes IDH1/2 por PCR.
2. Dinâmica e Etapas do Programa
2.1 O Médico deverá realizar seu cadastro no Programa e aceitar os termos do aviso de privacidade uma única vez.
2.2. Solicitando Participação do Paciente no Programa
(a) O Médico deverá preencher, na área logada do Site do Programa, todos os dados necessários do Paciente e o laboratório ao qual deverá ser encaminhada a amostra;
(b) O Médico deve comunicar ao paciente que está realizando o preenchimento desses dados e que os mesmos serão processados apenas após aceite de link a ser enviado para o Paciente;
(c) O Médico deverá fornecer um pedido médico para a realização do teste, assinado e carimbado, o qual deverá ser anexado na Plataforma;
(d) Colangiocarcinoma e Glioma difuso do tipo adulto: O Médico deverá fornecer uma cópia do resultado do exame anatomopatológico que também deverá ser anexado na Plataforma;
(e) Glioma difuso do tipo adulto de grau 2: O Médico também deverá fornecer uma cópia do resultado negativo no teste de imuno-histoquímica da mutação IDH1 R132H para pacientes diagnosticados com glioma difuso do tipo adulto, o qual deverá ser anexado na Plataforma;
(f) Leucemia Mieloide Aguda: o médico deverá fornecer uma cópia do resultado da imunofenotipagem e/ou mielograma que também devera ser anexado na Plataforma;
(g) Caso necessário, o Médico e/ou Paciente deverão fornecer um pedido para que seja autorizado a retirado do seu material biológico no laboratório de origem e encaminhado ao laboratório parceiro que realizará o teste para identificação da mutação.
2.3. Concluindo o registro e agendando um exame
(a) O paciente deverá acessar o link enviado por e-mail/ WhatsApp e confirmar os dados pessoais preenchidos pelo médico;
(b) Posteriormente, deverá aceitar e concordar com o Termo de Consentimento enviado no mesmo link;
(c) A operadora do Programa entrará em contato com o laboratório de origem ou hospital para agendar a retirada do material (bloco de parafina/ sangue periférico/ amostra de medula óssea) e enviar as informações ao laboratório Parceiro escolhido.
2.4 Ao inscrever-se, o Médico pode autorizar o envio de materiais informativos, através de e-mail, WhatsApp ou contato telefônico. Para não receber mais tais materiais, basta entrar em contato com a Central de Atendimento no número 0800 703 3431 ou enviar um e-mail para [email protected].
2.5 Em caso de dúvida, ou alteração nos dados cadastrais, entre em contato com a Central de Atendimento.
2.6. Conduzindo o teste molecular.
O laboratório não iniciará a análise das amostras antes da confirmação de que os requisitos destacados neste regulamento foram atendidos, ou seja:
- Termo de consentimento assinado pelo paciente ou responsável;
- Pedido médico assinado e carimbado.
(a) Nos casos de colangiocarcinoma:
- Laudo anatomopatológico confirmando o diagnóstico de colangiocarcinoma ou padrão pancreato-biliar. Na ausência deste laudo, também será aceito um laudo radiológico com suspeita de colangiocarcinoma.
(b) Nos casos de glioma difuso do tipo adulto de grau 2:
- Laudo anatomopatológico confirmando o diagnóstico de glioma difuso do tipo adulto de grau 2;
- Resultado de imuno-histoquímica negativo para pesquisa do gene IDH1.
(c) Nos casos de Leucemia Mieloide Aguda Recém Diagnosticada inelegível a Quimioterapia intensiva ou Recidivada/Refratária:
- Laudo imunofenotipagem e/ou mielograma confirmando o diagnóstico de Leucemia Mieloide Aguda Recem Diagnosticada ou Recidivada/Refratária;
2.7. Disponibilidade de Resultados
(a) O resultado do exame será anexado no Site para acesso exclusivo do Profissional Médico;
(b) O Programa enviará um e-mail para o endereço de e-mail informado pelo médico no ato do cadastro para informar sobre a disponibilidade do resultado do teste na plataforma do Programa.
2.8. O Profissional Médico e o Paciente concordam e reconhecem que a Servier não será responsável por qualquer falha ou erro em qualquer uma das etapas acima realizadas por terceiros, inclusive no que diz respeito ao desempenho, qualidade e possíveis erros ou falhas nos testes, ficando isentos de qualquer responsabilidade a esse respeito, que recairá sobre terceiros.
2.9. O prazo para entrega dos resultados pode variar em função de diversos fatores externos; entretanto, para colangiocarcinoma e glioma difuso, o tempo estimado é de 15 a 20 dias úteis, e para leucemia mieloide aguda, de 3 a 5 dias úteis.
3. Vigência, Cancelamento e Exclusão do Programa
3.1. O Programa permanecerá em vigor por prazo indeterminado, podendo ser alterado, suspenso, interrompido ou encerrado, a qualquer momento, pela Servier, mediante comunicação feita no Site ou por aviso prévio de no mínimo 48 horas, realizado pela Central de Atendimento por telefone, e-mail ou notificação enviada para o endereço dos Profissionais Médicos Registrados.
3.2. Profissionais Médicos e Pacientes podem cancelar sua participação no Programa entrando em contato com a Central de Atendimento do Programa no número 0800 703 3431 ou enviando uma mensagem para [email protected]. Neste cenário, qualquer serviço ou informação pendente do Programa será interrompido imediatamente.
3.3. Os Profissionais Médicos poderão ter sua participação no Programa revogada nos seguintes casos:
(a) Informações inconsistentes ou imprecisas fornecidas pelo Profissional Médico;
(b) O Profissional Médico utiliza os benefícios do Programa de forma indevida ou concede benefícios a terceiros específicos.
3.4. O cadastro do paciente no Programa será revogado caso ocorra uma das seguintes situações:
(a) Pedido do paciente, cuidador ou responsável legal para desvinculação da participação no Programa;
(b) Pacientes cadastrados mais de uma vez. Neste caso, apenas um registro será mantido no sistema;
(c) Em caso de morte do paciente;
(d) Assim que o paciente elegível tiver concluído todos os serviços oferecidos pelo Programa, sua inscrição será encerrada para garantir que ele não receba serviços adicionais.
3.5. A Aditus Health poderá manter os dados pessoais dos Pacientes que tenham revogado o seu consentimento para o processamento de dados se tais dados forem necessários, e na medida exata em que for necessário, para (i) cumprimento de obrigações legais e regulamentares relacionadas com o Programa; ou para (ii) regular exercício de direitos, em contrato ou processo, especialmente para assegurar o cumprimento do disposto neste Regulamento e não haver abuso do Programa por parte do Paciente ou Profissionais de Saúde.
4. Confidencialidade e privacidade de dados
4.1. Em atendimento à Lei nº 13.709/2018 – Lei Geral de Proteção de Dados ("LGPD"), todos os dados pessoais fornecidos por Profissionais Médicos e Pacientes/Responsável Legal para participação no Programa serão tratados de acordo com os princípios e nas premissas legais, conforme descrito no link: https://www.idhentifique.com.br.
4.2. Ao registar-se e solicitar a adesão ao Programa, será solicitado o consentimento do titular dos dados (Paciente) de forma livre, informada e inequívoca. Caso o titular dos dados opte por não fornecer os seus dados pessoais ou pretenda revogar o seu consentimento para o tratamento, não será permitida a continuação da participação do titular dos dados no Programa, uma vez que os dados pessoais recolhidos são essenciais às atividades do Programa.
4.3. Para confirmar o diagnóstico do Paciente e confirmar sua elegibilidade para o Programa, dados de saúde, como o laudo anatomopatológico, imunofenotipagem e mielograma podem ser processados. Para esta categoria de dados, o Gestor adota medidas técnicas adicionais para garantir a segurança e privacidade dos dados pessoais.
4.4. Todos os dados pessoais serão tratados de forma confidencial, exclusivamente para a operacionalização do Programa, de acordo com os princípios estabelecidos pela LGPD, em atividades como atendimento de obrigações legais ou regulamentares, suporte e comunicação com o Paciente, pesquisa e desenvolvimento de novos produtos e serviços, a satisfação dos direitos dos titulares, etc., tendo sempre em atenção o superior interesse dos titulares dos dados.
4.5. O Gestor também é responsável por manter seu banco de dados em ambiente seguro, com acesso restrito, garantindo sua integridade e confidencialidade.
4.6. Os dados pessoais tratados poderão ser partilhados pela Gestora com outras empresas do grupo, parceiros comerciais e fornecedores de produtos e serviços, exclusivamente para a sua operacionalização. Também poderá haver o compartilhamento de dados com o Poder Público e Órgãos Reguladores oficiais, em caso de solicitação destes e/ou necessidade regulatória ou legal. A Gestora poderá, por sua vez, contratar e subcontratar prestadores de serviços terceirizados para realizar o tratamento de dados pessoais ou parte deles, caso em que tais prestadores serão devidamente avaliados e aprovados pela Gestora e pela Servier, ficando também sujeitos aos mesmos requisitos de segurança, confidencialidade e lealdade no tratamento dos dados pessoais no âmbito do Programa aplicável à Servier e à Gestora.
4.7 Os dados pessoais do Paciente, incluindo o resultado do teste, poderão ser usados para avaliações científicas e estatísticas, incluindo publicações científicas, desde que sejam utilizados de forma anonimizada. Ou seja, a utilização para essas finalidades ocorrerá de forma que não seja possível identificar nem o médico e nem o Paciente.
4.8. Em caso de dúvidas sobre a coleta e utilização dos seus dados pessoais, acesso o nosso Aviso de Privacidade e consulte o nosso FAQ. Caso tenha alguma dúvida específica, envie seu questionamento para o seguinte endereço: [email protected].
5. Declarações
5.1. O Paciente e o Profissional Médico declaram, garantem e reconhecem que:
(a) São plenamente capazes, possuem todos os poderes necessários para outorgar os direitos e cumprir com suas obrigações decorrentes deste Contrato, são qualificados e autorizados e não possuem qualquer tipo de impedimento funcional para se cadastrar e/ou participar do Programa, possuindo todas as autorizações necessárias para o exercício das atividades aqui descritas;
(b) Não possuem conflito de interesse para participar do Programa;
(c) O suporte diagnóstico para a identificação das mutações em IDH em pacientes com colangiocarcinoma, glioma difuso do tipo adulto ou Leucemia Mieloide Aguda, oferecido pela Servier no âmbito deste Programa não criará qualquer obrigação da Servier em apoiar o Paciente e/ou Profissional Médico em relação ao tratamento do colangiocarcinoma, glioma difuso do tipo adulto de grau 2 ou Leucemia Mieloide Aguda.
(d) Estão cientes e entendem que os benefícios do Programa não (i) implicam ou implicarão, a qualquer momento, uma obrigação do Profissional Médico e/ou do Paciente de indicar, apoiar ou endossar a Servier ou qualquer um de seus produtos, nem a necessidade e/ou dever de retribuir e/ou recompensar a Servier, de qualquer forma e (ii) se destina a fornecer benefícios a um funcionário público ou a terceiros que possam influenciar a prescrição, compra ou uso dos produtos Servier, nem está sendo concedida para obter um benefício indevido ou impróprio para a Servier.
5.2. O Profissional Médico e o Paciente, conforme o caso, comprometem-se a indenizar integralmente, isentar e defender a Servier de e contra quaisquer danos, custas e despesas, incluindo custas judiciais e processuais, incorridos em razão de qualquer reclamação decorrente do facto de não ter os poderes necessários para se cadastrar e/ou participar do Programa.
6. Central de Atendimento
6.1. A Central de Atendimento estará disponível para atendimento das 8h às 17h (horário de Brasília), de segunda a sexta-feira, exceto feriados nacionais, através do telefone: 0800 703 3431 ou do e-mail de contato: [email protected].
7. Disposições Gerais
7.1. Todas as questões que os Pacientes possam ter relativamente à doença, tratamento ou diagnóstico devem ser dirigidas ao Profissional Médico.
7.2. As partes deste Regulamento são contratantes independentes e nada neste Regulamento do Programa pode ser interpretado como constituindo uma parceria, ou qualquer outro tipo de associação, formal ou informal, com a Servier.
7.3. A nulidade de qualquer cláusula ou condição destas Regras do Programa não afetará a validade ou execução de suas demais cláusulas e condições. Caso alguma das cláusulas ou condições deste Regulamento seja considerada nula, inválida ou inexequível, as partes se comprometem a negociar de boa-fé a substituição da referida cláusula ou condição por outra cláusula ou condição equivalente, válida, eficaz e exequível.
7.4. Todas as comunicações relativas ao Programa poderão ser encaminhadas à Central de Atendimento, através dos canais disponíveis indicados na cláusula 6.
Estas Regras do Programa podem ser revisadas e atualizadas periodicamente pela Servier. Sempre que atualizado, o Profissional Médico receberá notificação, por e-mail ou por telefone, de tais alterações, devendo prontamente manifestar sua concordância com tais alterações, expressamente ou por conduta que demonstre inequivocamente sua concordância, sob pena de exclusão do programa. Para participar do Programa, o participante deve concordar com os termos do Regulamento e da Link da Política de Privacidade estabelecidos.
- Mutações pesquisadas por NGS em pacientes com colangiocarcinoma:
- Laboratório 1: OC Medicina de Precisão (Oncoclínicas): AKT1, ALK, ATM, BRAF, BRCA1, BRCA2, EGFR, ERBB2, ESR1, FGFR3, HRAS, IDH1, IDH2, KIT, KRAS, MET (éxon 14), NRAS, PALB2, PDGFRA, PIK3CA, POLE, RET, TP53;
- Laboratório 2: (Rede DASA): DNA – MUTAÇÕES PONTUAIS E INDELS: AKT1, AKT2, AKT3, ALK, AR, ARAF, BRAF, CDK4, CDKN2A, CHEK2, CTNNB1, EGFR, ERBB2, ERBB3, ERBB4, ESR1, FGFR1, FGFR2, FGFR3, FGFR4, FLT3, GNA11, GNAQ, POLE, GNAS, HRAS, IDH1, IDH2, KIT, KRAS, MAP2K1, MAP2K2, MET, MTOR, NRAS, NTRK1, NTRK2, NTRK3, PDGFRA, PIK3CA, PTEN, RAF1, RET, ROS1, SMO, TP53, STK11, KEAP1. CNVs: ALK, AR, CD274, CDKN2A, EGFR, ERBB2, ERBB3, FGFR1, FGFR2, FGFR3, KRAS, MET, PIK3CA e PTEN;
- Laboratório 3 (Rede D'Or): AKT1-3, ALK, ARAF, AR, BRAF, CDK4, CDKN2A, CHEK2, CTNNB1, EGFR, ERBB2-4, ESR1, FGFR1-3, FLT3, GNAQ, GNA11, GNAS, HRAS, IDH1-2, KIT, KRAS, MAP2K1-2, MET, MTOR, NRAS, NTRK1-3, PDGFRA, PIK3CA, PTEN, NRAS, RAF1, RET, ROS1, SMO, TP53;
- Laboratório 4: Hospital de Amor (Hospital do Câncer de Barretos): IDH1 éxon 4 (códon 132), IDH2 éxon 4 (códons 140 e 172), BRAF éxon 15 (códon 600), KRAS éxon 2 (códons 12 e 13) e MSI (instabilidade de microssatélite);
- Laboratório 5: (A.C. Camargo Cancer Center): BRAF, EGFR, ERBB2, HRAS, IDH1, IDH2, JAK2, KIT, KRAS, MET, NRAS, PDGFRA, PIK3CA e ROS.
- Mutações pesquisadas por NGS em pacientes com glioma difuso do tipo adulto de grau 2:
- Laboratório 1: OCPM (Oncoclínicas): MUTAÇÕES SNV E INDEL: 29 genes, cobertura IDH1 (éxons 3 e 4), IDH2 (éxon 3), CDKN2A, CDKN2B, TERT, H3F3A (éxon 2); CNV: 6 genes, incluindo EGFR, CDKN2A, CDKN2B;
- Laboratório 2: (Rede DASA): DNA – MUTAÇÕES PONTUAIS E INDELS: AKT1, AKT2, AKT3, ALK, AR, ARAF, BRAF, CDK4, CDKN2A, CHEK2, CTNNB1, EGFR, ERBB2, ERBB3, ERBB4, ESR1, FGFR1, FGFR2, FGFR3, FGFR4, FLT3, GNA11, GNAQ, POLE, GNAS, HRAS, IDH1, IDH2, KIT, KRAS, MAP2K1, MAP2K2, MET, MTOR, NRAS, NTRK1, NTRK2, NTRK3, PDGFRA, PIK3CA, PTEN, RAF1, RET, ROS1, SMO, TP53, STK11, KEAP1. CNVs: ALK, AR, CD274, CDKN2A, EGFR, ERBB2, ERBB3, FGFR1, FGFR2, FGFR3, KRAS, MET, PIK3CA, PTEN;
- Laboratório 3 (Rede D'Or): AKT1-3, ALK, ARAF, AR, BRAF, CDK4, CDKN2A, CHEK2, CTNNB1, EGFR, ERBB2-4, ESR1, FGFR1-3, FLT3, GNAQ, GNA11, GNAS, HRAS, IDH1-2, KIT, KRAS, MAP2K1-2, MET, MTOR, NRAS, NTRK1-3, PDGFRA, PIK3CA, PTEN, RAF1, RET, ROS1, SMO, TP53;
- Laboratório 4: Hospital de Amor (Hospital do Câncer de Barretos): BRAF éxon 15 (códon 600), IDH1 éxon 4, IDH2 éxon 4, H3F3A éxon 2, HIST1H3B éxon 2, TERT promotor, FGFR1 éxon 13 e 14, EGFR amplificação e CDKN2A deleção homozigótica;
- Laboratório 5: (A.C. Camargo Cancer Center): BRAF, EGFR, ERBB2, HRAS, IDH1, IDH2, JAK2, KIT, KRAS, MET, NRAS, PDGFRA, PIK3CA e ROS.
- Mutações pesquisadas por PCR em pacientes com Leucemia Mieloide Aguda Recém Diagnosticada ou Recidivada/Refratária:
- Laboratório 1 (Uniscience do Brasil): IDH1/IDH2 – plataforma Uniscience Molecular (Idylla);
- Laboratório 2 OCPM (Oncoclínicas): IDH1/IDH2.
Última atualização: 14/10/2025